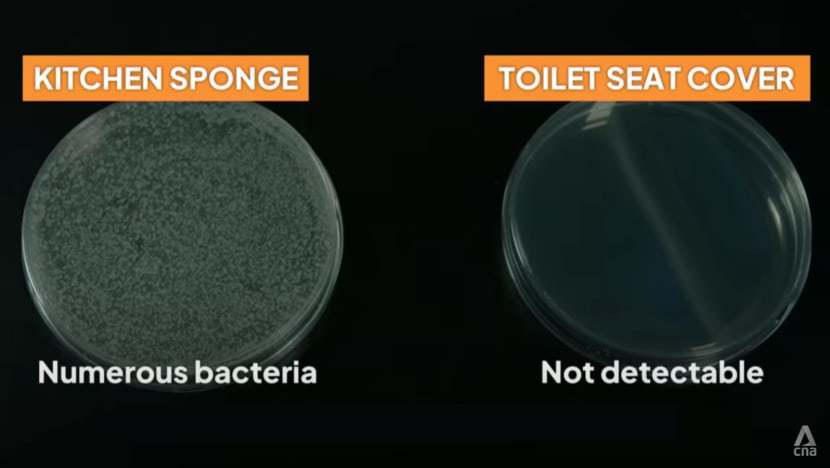
When to Replace Your Scrubber Or Sponge to Avoid Bacteria

You use your scrubber or sponge every day to clean dishes, countertops, and even fruits and vegetables. But have you ever stopped to think about how often you should replace it?
If you hold on to your scrubber or sponge for too long, it can become a breeding ground for harmful bacteria—putting your health at risk without you even realizing it. You’ll discover the clear signs that tell you it’s time to swap out your cleaning tools.
Keep reading to protect yourself and your family from unseen germs lurking right in your kitchen.

Credit: tidyhere.com
Signs Your Scrubber Or Sponge Needs Replacement
Knowing when to replace your scrubber or sponge is crucial to keep your kitchen hygienic and avoid bacteria buildup. These tools can quickly become breeding grounds for germs if not swapped out regularly. Pay attention to specific signs that indicate it’s time to get a fresh one.
Visible Wear And Tear
If your scrubber or sponge looks worn out, it’s a clear signal to replace it. Torn edges, frayed fibers, or crumbling material reduce its ability to clean effectively. Have you noticed your sponge losing its shape or falling apart after just a few uses? That’s a sign it’s past its prime.
Persistent Odors
Does your sponge smell bad even after rinsing and drying? Persistent odors often mean bacteria have taken hold. No amount of rinsing or soaking in vinegar will fix that smell. If your scrubber emits a foul odor, it’s time to toss it and grab a new one.
Reduced Cleaning Effectiveness
When your scrubber or sponge doesn’t clean as well as before, it’s a warning sign. You might find yourself scrubbing harder or using more detergent without the usual results. If cleaning feels like a chore and spots or grime remain, replacing your tool can save you time and effort.
Bacteria Growth Risks In Old Sponges And Scrubbers
Old sponges and scrubbers are perfect places for bacteria to grow. They stay wet and collect food particles, which helps germs multiply fast. Using these dirty cleaning tools can spread bacteria around your kitchen. This increases the risk of illnesses and infections.
Knowing the types of bacteria found in old sponges helps understand the danger. Being aware of health risks makes it clear why regular replacement is important.
Common Bacteria Found
- E. coli:Found in raw food and feces, causes stomach illness.
- Salmonella:Comes from raw meat, leads to food poisoning.
- Staphylococcus aureus:Lives on skin and nose, causes infections.
- Listeria:Found in soil and water, harmful to pregnant women.
- Pseudomonas aeruginosa:Grows in moist places, can cause infections.
Health Implications
Bacteria from old sponges can cause food poisoning. Symptoms include nausea, vomiting, and diarrhea. Some infections can become serious, especially for kids and elderly people.
Using contaminated scrubbers can spread germs to kitchen surfaces. This increases the risk of cross-contamination. Germs can transfer to food, causing sickness.
Regularly changing your sponges and scrubbers helps keep your kitchen safe. It reduces bacteria growth and protects your health.
Recommended Replacement Frequency
Knowing how often to replace your scrubber or sponge is crucial to keeping your kitchen germ-free. Bacteria can build up quickly on these cleaning tools, sometimes faster than you expect. Setting a clear replacement schedule helps you avoid unwanted health risks and maintain a clean space.
Daily Use Guidelines
If you use your scrubber or sponge every day, aim to replace it every 1 to 2 weeks. This frequent turnover stops bacteria from multiplying to dangerous levels.
In between replacements, give your sponge a daily rinse and squeeze out excess water to slow bacterial growth. You might also consider microwaving a damp sponge for about 1 minute to kill germs. However, this should not replace regular replacement.
Factors Affecting Lifespan
Not all sponges last the same amount of time. The material type, how often you use it, and what you clean with it all impact its lifespan.
- Material:Natural sponges might degrade faster than synthetic ones, requiring more frequent replacement.
- Cleaning tasks:If you use your scrubber on raw meat or heavy grease, replace it sooner to avoid cross-contamination.
- Storage:Leaving your sponge wet or in a dark, warm spot encourages bacterial growth and shortens its usability.
Have you ever kept a sponge too long and noticed a bad smell or slimy feel? That’s a clear sign it’s time for a new one. Trust your senses—they often tell you when replacement is overdue.
Tips To Prolong Sponge And Scrubber Life
Extending the life of your scrubbers and sponges keeps them clean and safe. Proper care helps reduce bacteria growth and saves money. Follow simple tips to keep these cleaning tools fresh and effective for longer.
Proper Cleaning Techniques
- Rinse sponges and scrubbers thoroughly after each use.
- Use hot water and soap to remove food and grease.
- Sanitize regularly by microwaving damp sponges for one minute.
- Alternatively, soak sponges in a bleach solution for five minutes.
- Avoid using sponges on raw meat surfaces to limit bacteria.
Drying And Storage Advice
- Allow scrubbers and sponges to dry completely between uses.
- Store them in a well-ventilated area to prevent moisture buildup.
- Use a sponge holder that drains water away from the sponge.
- Replace storage containers regularly to avoid mold growth.
- Never leave sponges sitting in a wet sink or dishwater.
Alternatives To Traditional Sponges And Scrubbers
Traditional sponges and scrubbers can become breeding grounds for bacteria if not replaced regularly. Fortunately, there are alternative cleaning tools that are more hygienic and longer-lasting. These alternatives not only help keep your kitchen germ-free but also save you from frequent replacements. Ready to make the switch?
Silicone Scrubbers
Silicone scrubbers are a fantastic option due to their non-porous nature. Unlike traditional sponges, they don’t absorb water and food particles, reducing the risk of bacterial growth. They’re also easy to clean, often requiring just a rinse or a run through the dishwasher. Have you ever noticed your sponge smelling funky after a few uses? Silicone scrubbers eliminate this problem entirely. Their durability means you can use them for months without needing a replacement.
Microfiber Cloths
Microfiber cloths are another excellent alternative. They are incredibly effective at picking up dirt and grime without scratching surfaces. These cloths can be used both wet and dry, making them versatile for various cleaning tasks. One surprising benefit is their ability to clean with just water, cutting down on the need for chemical cleaners. Plus, they’re machine washable, making them easy to maintain. Imagine the savings and convenience of having a reliable, reusable cleaning tool at your disposal.
Switching to these alternatives can transform your cleaning routine. Which option will you try first?

Credit: www.facebook.com
Safe Disposal Methods For Old Scrubbers And Sponges
Discarding old scrubbers and sponges safely is crucial to prevent bacteria spread and protect the environment. Many people toss these items in the trash without considering better options. But you can take simple steps to dispose of them responsibly while reducing waste.
Recycling Options
Most household scrubbers and sponges are made from synthetic materials that don’t break down easily. However, some brands offer recycling programs where you can send back used scrubbers. Check if your product’s manufacturer supports take-back or mail-in recycling.
You might also find local recycling centers that accept sponges and scrubbers, but this depends on their policies. Another option is to repurpose old sponges for cleaning tasks like wiping windows or dusting hard-to-reach spots before discarding them. This extends their life and reduces immediate waste.
Environmental Considerations
Throwing synthetic scrubbers into landfill contributes to plastic pollution. Over time, these materials can release microplastics, which harm wildlife and ecosystems. You can minimize this impact by choosing biodegradable or natural fiber scrubbers that break down faster.
Consider how often you replace your sponge and whether it’s truly necessary. Keeping a sponge too long increases bacteria, but replacing it too frequently adds waste. Balancing hygiene and environmental care means being mindful about disposal and choosing greener products.
Have you thought about the journey your scrubber takes after you toss it? Your small action can help reduce pollution and promote healthier habits in your home and community.

Credit: www.taste.com.au
Frequently Asked Questions
How Often Should You Replace Kitchen Sponges?
Replace kitchen sponges every one to two weeks. Frequent use and moisture cause bacteria buildup. Regular replacement ensures cleanliness and reduces health risks.
What Signs Indicate A Sponge Needs Replacing?
A sponge needs replacing if it smells bad, feels slimy, or has visible wear. These signs mean bacteria are growing and it’s no longer effective.
Can Scrubbing Brushes Harbor Bacteria Like Sponges?
Yes, scrubbing brushes can harbor bacteria if not cleaned properly. Replace them every one to three months or when bristles wear out.
Does Soaking Sponges In Bleach Kill Bacteria Effectively?
Soaking sponges in bleach helps kill bacteria but doesn’t eliminate all germs. Regular replacement is still necessary for hygiene and safety.
Conclusion
Replacing your scrubber or sponge often keeps your kitchen clean. Old sponges hold germs that can make you sick. Change them every one to two weeks for safety. Notice a bad smell or tears? Time to get a new one.
Clean tools help stop bacteria from spreading. Small steps protect your family’s health daily. Keep your kitchen fresh and safe with regular replacements. Simple habits make a big difference in hygiene. Don’t wait—stay ahead and keep your home healthy.